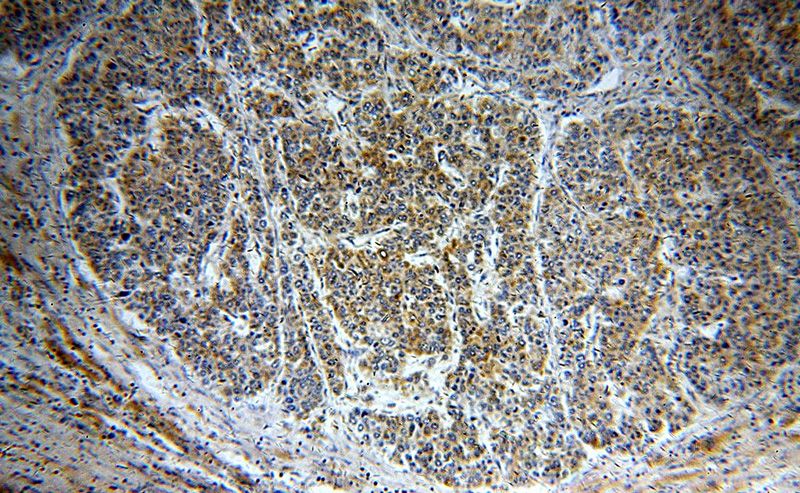
Immunohistochemical of paraffin-embedded human liver cancer using Catalog No:109984(DKK3 antibody) at dilution of 1:50 (under 10x lens)
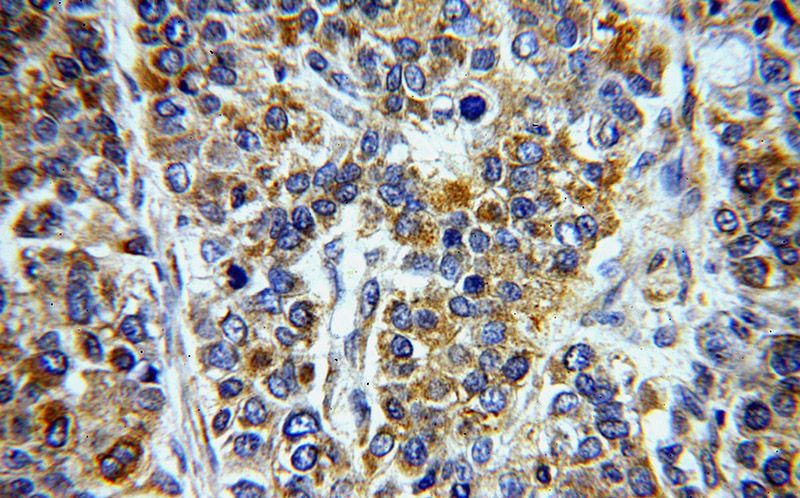
Immunohistochemical of paraffin-embedded human liver cancer using Catalog No:109984(DKK3 antibody) at dilution of 1:50 (under 40x lens)

-
Product Name
DKK3 antibody
- Documents
-
Description
DKK3 Rabbit Polyclonal antibody. Positive FC detected in HepG2 cells. Positive IF detected in SH-SY5Y cells. Positive IHC detected in human liver cancer tissue, mouse brain tissue. Positive WB detected in mouse brain tissue, human brain tissue, Transfected HEK-293 cells. Observed molecular weight by Western-blot: 55 kDa
-
Tested applications
ELISA, WB, IHC, FC, IF
-
Species reactivity
Human, Mouse; other species not tested.
-
Alternative names
Dickkopf 3 antibody; Dickkopf related protein 3 antibody; Dkk 3 antibody; DKK3 antibody; hDkk 3 antibody; REIC antibody; RIG antibody
-
Isotype
Rabbit IgG
-
Preparation
This antibody was obtained by immunization of DKK3 recombinant protein (Accession Number: NM_015881). Purification method: Antigen affinity purified.
-
Clonality
Polyclonal
-
Formulation
PBS with 0.1% sodium azide and 50% glycerol pH 7.3.
-
Storage instructions
Store at -20℃. DO NOT ALIQUOT
-
Applications
Recommended Dilution:
WB: 1:200-1:2000
IHC: 1:20-1:200
IF: 1:20-1:200
-
Validations

mouse brain tissue were subjected to SDS PAGE followed by western blot with Catalog No:109984(DKK3 antibody) at dilution of 1:500
Immunohistochemical of paraffin-embedded human liver cancer using Catalog No:109984(DKK3 antibody) at dilution of 1:50 (under 10x lens)
Immunohistochemical of paraffin-embedded human liver cancer using Catalog No:109984(DKK3 antibody) at dilution of 1:50 (under 40x lens)

Transfected HEK-293 cells were subjected to SDS PAGE followed by western blot with Catalog No:109984(DKK3 Antibody) at dilution of 1:1000

Immunofluorescent analysis of SH-SY5Y cells using Catalog No:109984(DKK3 Antibody) at dilution of 1:50 and Alexa Fluor 488-congugated AffiniPure Goat Anti-Rabbit IgG(H+L)

1X10^6 HepG2 cells were stained with 0.2ug DKK3 antibody (Catalog No:109984, red) and control antibody (blue). Fixed with 90% MeOH blocked with 3% BSA (30 min). Alexa Fluor 488-congugated AffiniPure Goat Anti-Rabbit IgG(H+L) with dilution 1:1000.
-
Background
DKK3, also named as REIC, belongs to the dickkopf family. It antagonizes canonical Wnt signaling by inhibiting LRP5/6 interaction with Wnt and by forming a ternary complex with the transmembrane protein KREMEN that promotes internalization of LRP5/6. DKKs play an important role in vertebrate development, where they locally inhibit Wnt regulated processes such as antero-posterior axial patterning, limb development, somitogenesis and eye formation. In the adult, Dkks are implicated in bone formation and bone disease, cancer and Alzheimer's disea. The adenovirus carrying REIC/Dkk-3 (Ad-REIC) exhibits a potent tumor-specific cell-killing function for various human cancers. It has also become evident that some human cancers are resistant to Ad-REIC-induced apoptosis. The DKK3 is a Glycosylation protein with MW about 55 kDa or 38-43 kDa.
-
References
- Ueno K, Hirata H, Majid S. Wnt antagonist DICKKOPF-3 (Dkk-3) induces apoptosis in human renal cell carcinoma. Molecular carcinogenesis. 50(6):449-57. 2011.
- Ueno K, Hirata H, Shahryari V. microRNA-183 is an oncogene targeting Dkk-3 and SMAD4 in prostate cancer. British journal of cancer. 108(8):1659-67. 2013.
- Li X, Xu Y, Chen Y. SOX2 promotes tumor metastasis by stimulating epithelial-to-mesenchymal transition via regulation of WNT/β-catenin signal network. Cancer letters. 336(2):379-89. 2013.
- Ochiai K, Watanabe M, Azakami D. Molecular cloning and tumour suppressor function analysis of canine REIC/Dkk-3 in mammary gland tumours. Veterinary journal (London, England : 1997). 197(3):769-75. 2013.
- Zhu Y, Demidov ON, Goh AM, Virshup DM, Lane DP, Bulavin DV. Phosphatase WIP1 regulates adult neurogenesis and WNT signaling during aging. The Journal of clinical investigation. 124(7):3263-73. 2014.
Related Products / Services
Please note: All products are "FOR RESEARCH USE ONLY AND ARE NOT INTENDED FOR DIAGNOSTIC OR THERAPEUTIC USE"
